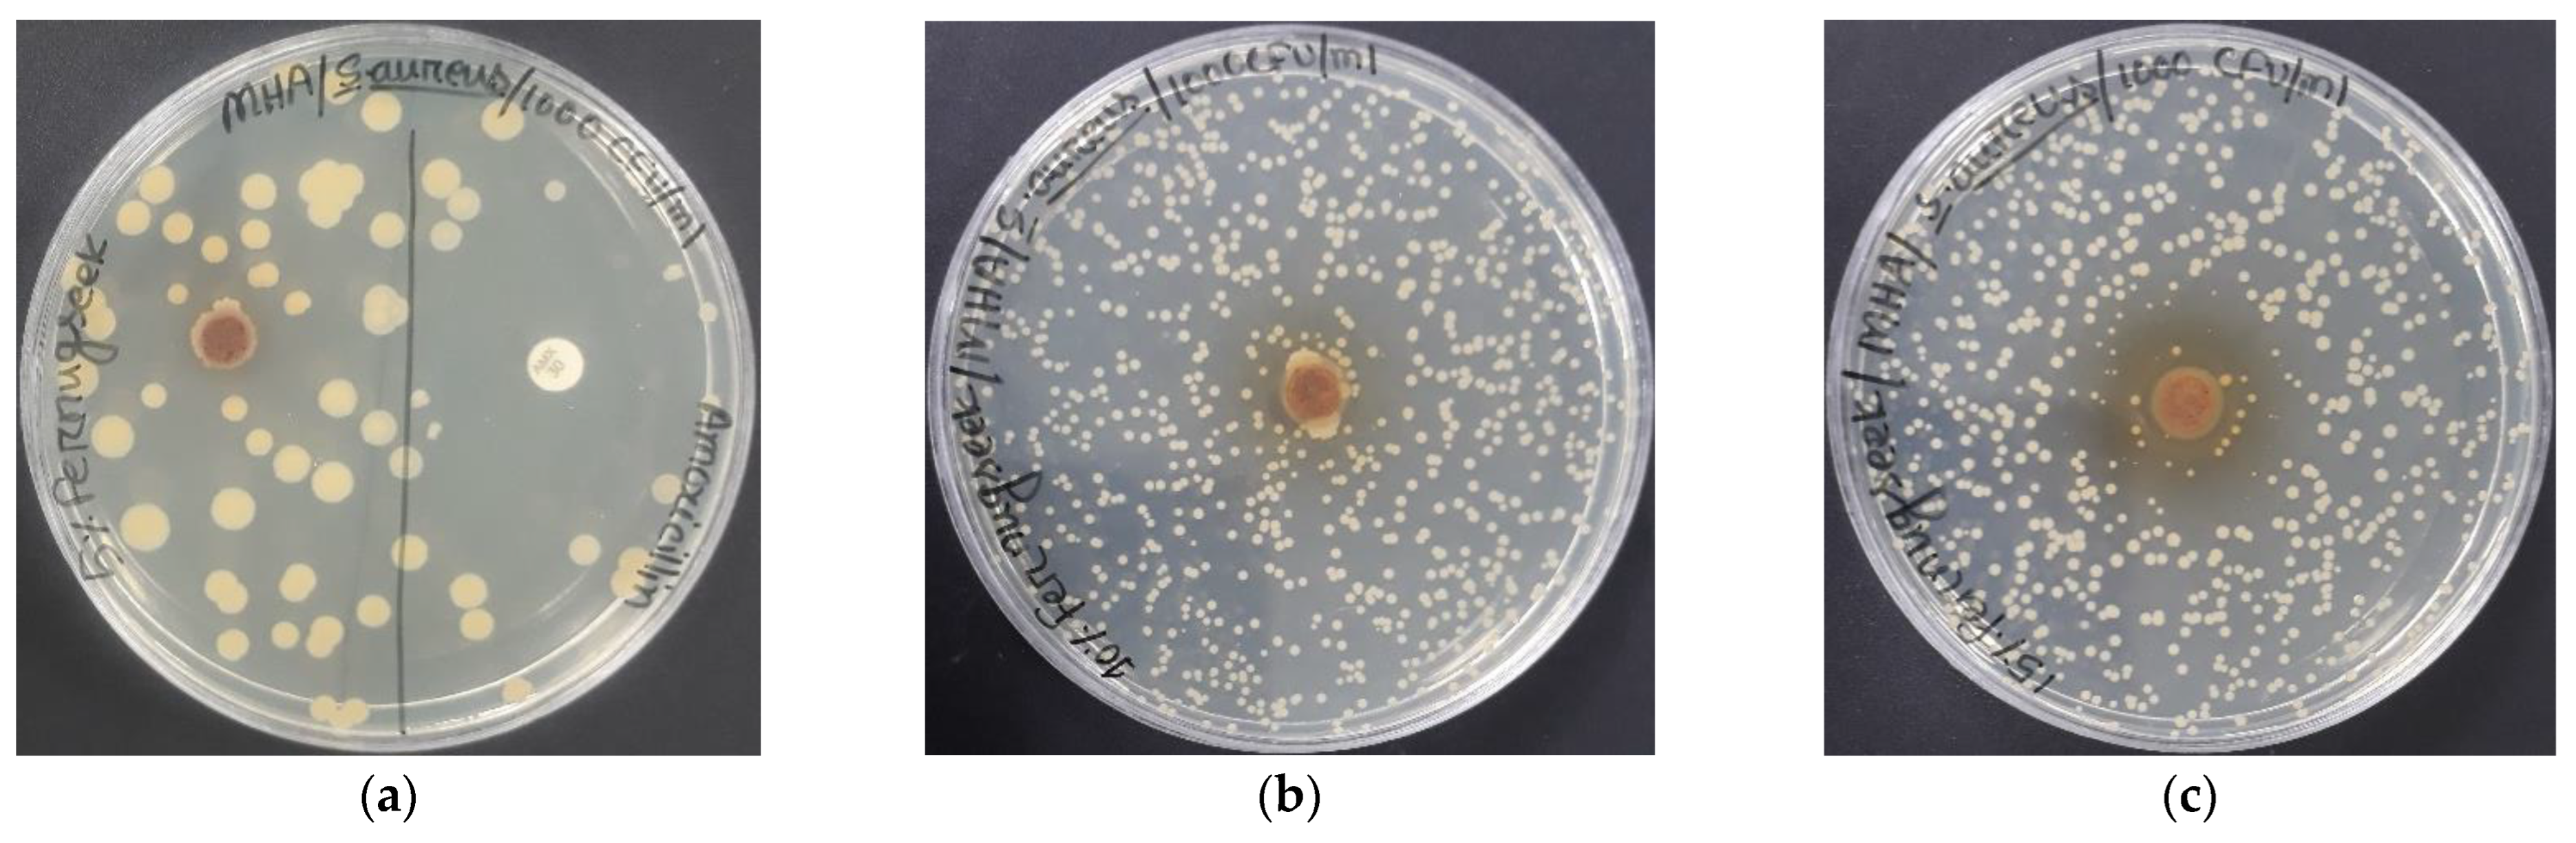
Polymers 14 05141 g013 Polymers 14 05141 g013

Synthesis and Characterization of Eco-Friendly Bio-Composite from Fenugreek as a Natural Resource
Abstract
1. Introduction
2. Materials and Methodology
2.1. Materials
2.2. Production of Bio-Composite
2.3. Characterization
2.3.1. Biodegradation Test
2.3.2. Mechanical Test
2.3.3. Scanning Electron Microscopy Test
2.3.4. X-ray Diffraction Test
2.3.5. Thermal Analysis
2.3.6. Antimicrobial Test
3. Results and Discussion
3.1. Biodegradation
3.2. Tensile Strength
3.3. Scanning Electron Microscopy
3.4. X-ray Diffraction Analysis
3.5. Thermal Analysis
3.6. Antibacterial Activity
4. Conclusions
Author Contributions
Funding
Institutional Review Board Statement
Informed Consent Statement
Data Availability Statement
Acknowledgments
Conflicts of Interest
References
- Sanyang, M.; Sapuan, S.; Jawaid, M.; Ishak, M.; Sahari, J. Effect of plasticizertype and concentration on tensile, thermal and barrier properties of biodegradable films based on sugar palm (Arengapinnata) starch. Polymers 2015, 7, 1106–1124. [Google Scholar] [CrossRef]
- Lebreton, L.; Andrady, A. Future scenarios of global plastic waste generation and disposal. Palgrave Commun. 2019, 5, 6. [Google Scholar] [CrossRef]
- Blank, L.M.; Narancic, T.; Mampel, J.; Tiso, T.; O’Connor, K. Biotechnological upcycling of plastic waste and other non-conventional feedstocks in a circulareconomy. Curr. Opin. Biotechnol. 2020, 62, 212–219. [Google Scholar] [CrossRef]
- Jogi, K.; Bhat, R. Valorization of food processing wastes and by-products for bioplastic production. Sustain. Chem. Pharm. 2020, 18, 100326. [Google Scholar] [CrossRef]
- Méité, N.; Konan, L.K.; Tognonvi, M.T.; Doubi, B.I.H.G.; Gomina, M.; Oyetola, S. Properties of hydric and biodegradability of cassava starch-based bio-composites reinforced with thermally modified kaolin. Carbohydr. Polym. 2021, 254, 117322. [Google Scholar] [CrossRef]
- European Bioplastic. 2020. Bioplastic Market Data 2019 [WWW Document]. Available online: https://docs.european-bioplastic.org/publications/market_data/Report_Bio-composites_Market_Data_2019.pdf (accessed on 21 September 2020).
- Plastics Europe. 2020. Plastics: The Facts 2019 [WWW Document]. Available online: https://www.plasticseurope.org/application/fles/9715/7129/9584/FINAL_web_version_Plastics_the_facts2019_14102019.pdf (accessed on 10 June 2020).
- Morone, P.; Koutinas, A.; Gathergood, N.; Arshadi, M.; Matharu, A. Food waste: Challenges and opportunities for enhancing the emerging bio-economy. J. Clean. Prod. 2019, 221, 10–16. [Google Scholar] [CrossRef]
- Jiménez-Rosado, M.; Rubio-Valle, J.F.; Perez-Puyana, V.; Guerrero, A.; Romero, A. Use of heat treatment for the development of protein-based bioplastic. Sustain. Chem. Pharm. 2020, 18, 100341. [Google Scholar] [CrossRef]
- Amin, M.R.; Chowdhury, M.A.; Kowser, M.A. Characterization and performance analysis of composite bioplastic synthesized using titanium dioxide nanoparticles with corn starch. Heliyon 2019, 5, e02009. [Google Scholar] [CrossRef] [PubMed]
- Xie, F.; Pollet, E.; Halley, P.J.; Avérous, L. Starch-based nano-bioplastic. Prog. Polym. Sci. 2013, 38, 1590–1628. [Google Scholar] [CrossRef]
- Roy, K.; Thory, R.; Sinhmar, A.; Pathera, A.K.; Nain, V. Development and characterization of nano starch-based composite flms from mung bean (Vignaradiata). Int. J. Biol. Macromol. 2020, 144, 242–251. [Google Scholar] [CrossRef]
- Zoungranan, Y.; Lynda, E.; Dobi-Brice, K.K.; Tchirioua, E.; Bakary, C.; Yannick, D.D. Influence of natural factors on the biodegradation of simple and composite bioplastic based on cassava starch and corn starch. J. Environ. Chem. Eng. 2020, 8, 104396. [Google Scholar] [CrossRef]
- Peidayesh, H.; Ahmadi, Z.; Khonakdar, H.A.; Abdouss, M.; Chodák, I. Fabrication and properties of thermoplastic starch/Montmorillonite composite using dialdehyde starch as a crosslinker. Polym. Int. 2020, 69, 317–327. [Google Scholar] [CrossRef]
- Peidayesh, H.; Heydari, A.; Mosnáčková, K.; Chodak, I. In situ dual crosslinking strategy to improve the physico-chemical properties of thermoplastic starch. Carbohydr. Polym. 2021, 269, 118250. [Google Scholar] [CrossRef] [PubMed]
- Peidayesh, H.; Mosnáčková, K.; Špitalský, Z.; Heydari, A.; Šišková, A.O.; Chodák, I. Thermoplastic Starch–Based Composite Reinforced by Conductive Filler Networks: Physical Properties and Electrical Conductivity Changes during Cyclic Deformation. Polymers 2021, 13, 3819. [Google Scholar] [CrossRef] [PubMed]
- Paluch, M.; Ostrowska, J.; Tyński, P.; Adurski, W.; Konkol, M. Structural and Thermal Properties of Starch Plasticized with Glycerol/Urea Mixture. J. Polym. Environ. 2022, 30, 728–740. [Google Scholar] [CrossRef]
- Meghwal, M.; Goswami, T.K. A review on the functional properties, nutritional content, medicinal utilization and potential application of fenugreek. J. Food Process. Technol. 2012, 3, 9. [Google Scholar] [CrossRef]
- Wani, S.A.; Kumar, P. Fenugreek: A review on its nutraceutical properties and utilization in various food products. J. Saudi Soc. Agric. Sci. 2018, 17, 97–106. [Google Scholar] [CrossRef]
- Nagar, C.K.; Dash, S.K.; Rayaguru, K. Tamarind seed: Composition, applications, and value addition: A comprehensive review. J. Food Process. Preserv. 2022, 46, e16872. [Google Scholar] [CrossRef]
- Doharey, V.; Sharma, N. The permutation role of fenugreek seeds starch and Gunda glue as a binder in Paracetamol tablets. J. Pharm. Sci. Res. 2010, 2, 64–68. [Google Scholar]
- Pasha, I.; AsimShabbir, M.; Haider, M.A.; Afzal, B. Muhammad Farhan Jahangir Chughtai, Shabbir Ahmad and Muhammad SajidManzoor, Biochemical Evaluation of Trigonellafoenumgraecum (Fenugreek) with Special Reference to Phenolic Acids. Pak. J. Sci. Ind. Res. Ser. B Biol. Sci. 2017, 60, 154–161. [Google Scholar]
- Ghaffaripour, S.; van den Bilcke, N.; Samson, R. The importance of seed reserve on performance and breeding of tamarind seedlings. Sci. Hortic. 2017, 222, 145–152. [Google Scholar] [CrossRef]
- Okello, J.; John, B.; Okullo, L.; Eilu, G.; Nyeko, P.; Joseph, O. Physicochemical composition of Tamarindusindica L. (Tamarind) in the agro-ecological zones of Uganda. Food Sci. Nutr. 2018, 6, 1179–1189. [Google Scholar] [CrossRef] [PubMed]
- Okello, J.; John, B.; Okullo, L.; Eilu, G.; Nyeko, P.; Joseph, O. Mineral composition of Tamarindusindica LINN (tamarind) pulp and seeds from different agro-ecological zones of Uganda. Food Sci. Nutr. 2017, 5, 959–966. [Google Scholar] [CrossRef] [PubMed]
- Radhakrishnan, P.G.; Varghese, S.P.; Das, B.C. Application of ethylene diamine hydroxypropyl tamarind fruit shell as adsorbent to remove Eriochrome black T from aqueous solutions—Kinetic and equilibrium studies. Separ. Sci. Technol. 2018, 53, 417–438. [Google Scholar] [CrossRef]
- Mansingh, B.B.; Binoj, J.S.; PremSai, N.; Hassan, S.A.; Siengchin, S.; Sanjay, M.R.; Liu, Y.C. Sustainable development in utilization of Tamarindusindica L. and its by-products in industries: A review. Curr. Res. Green Sustain. Chem. 2021, 4, 100207. [Google Scholar] [CrossRef]
- Kumar, C.S.; Bhattacharya, S. Tamarind Seed: Properties, Processing and Utilization. Crit. Rev. Food Sci. Nutr. 2008, 48, 1–20. [Google Scholar] [CrossRef]
- Chowdhury, M.A.; Badrudduza, M.D.; Hossain, N.; Rana, M.M. Development and characterization of natural sourced bioplastic synthesized from tamarind seeds, berry seeds and licorice root. Appl. Surf. Sci. Adv. 2022, 11, 100313. [Google Scholar] [CrossRef]
- Shanmathy, M.; Mohanta, M.; Thirugnanam, A. Development of biodegradable bio-composite films from Taro starch reinforced with bentonite. Carbohydr. Polym. Technol. Appl. 2021, 2, 100173. [Google Scholar]
- Marichelvam, M.K.; Manimaran, P.; Sanjay, M.R.; Siengchin, S.; Geetha, M.; Kandakodeeswaran, K.; Boonyasopon, P.; Gorbatyuk, S. Extraction and development of starch-based bio-composites from Prosopis Juliflora Plant: Eco-friendly and sustainability aspects. Curr. Res. Green Sustain. Chem. 2022, 5, 100296. [Google Scholar] [CrossRef]
- Behera, L.; Mohanta, M.; Thirugnanam, A. Intensification of yam-starch based biodegradable bioplastic film with bentonite for food packaging application. Environ. Technol. Innov. 2022, 25, 102180. [Google Scholar] [CrossRef]
- Baidurah, S.; Takada, S.; Shimizu, K.; Ishida, Y.; Yamane, T.; Ohtani, H. Evaluation of biodegradation behavior of poly(butylene succinate-co-butylene adipate) with lowered crystallinity by thermally assisted hydrolysis and methylation-gas chromatography. J. Anal. Appl. Pyrolysis 2013, 103, 73–77. [Google Scholar] [CrossRef]
- Cucina, M.; Carlet, L.; De Nisi, P.; Somensi, C.A.; Giordano, A.; Adani, F. Degradation of bio-composites in organic waste by mesophilic anaerobic digestion, composting and soil incubation. Waste Manag. 2021, 134, 67–77. [Google Scholar] [CrossRef] [PubMed]
- Sachdeva, A.; Vashist, S.; Chopra, R.; Puri, D. Antimicrobial activity of active packaging film to prevent bread spoilage. Int. J. Food Sci. Nutr. 2017, 2, 29–37. [Google Scholar]
- Goncalves, S.M.; dos Santos, D.C.; Motta, J.F.G.; dos Santos, R.R.; Chavez, D.W.H.; de Melo, N.R. Structure and functional properties of cellulose acetate films incorporated with glycerol. Carbohydr. Polym. 2019, 209, 190–197. [Google Scholar] [CrossRef] [PubMed]
- Nigam, S.; Das, A.K.; Patidar, M.K. Synthesis, characterization and biodegradation of bio-composite films produced from Parthenium hysterophorus by incorporating a plasticizer (PEG600). Environ. Chall. 2021, 5, 100280. [Google Scholar] [CrossRef]
- Gaaz, T.S.; Sulong, A.B.; Akhtar, M.N.; Kadhum, A.A.; Mohamad, A.B.; Al-Amiery, A.A. Properties and applications of polyvinyl alcohol. Halloysite Nanotub. Nanocomposite Mol. 2015, 20, 22833–22847. [Google Scholar] [CrossRef]
- Jayakumar, S.; Bhuyar, P.; Pugazhendhi, A.; Rahim, M.H.; Maniam, G.P.; Govindan, N. Effects of lightintensity and nutrients on the lipid contentof marine microalga (diatom) Amphiprora sp. for promising biodiesel production. Sci. Total Environ. 2021, 768, 145471. [Google Scholar] [CrossRef]
- Rohmawati, B.; AtikahNataSya’idah, F.; Rhismayanti, R.; Alighiri, D.; Tirza Eden, W. Synthesis of bio-composite-based renewable cellulose acetate from teak wood (Tectonagrandis) biowaste using glycerol-chitosan plasticizer. Orient. J. Chem. 2018, 34, 1810–1816. [Google Scholar] [CrossRef]
- Kaith, B.S.; Mittal, H.; Jindal, R.; Maiti, M.; Kalia, S. Environment benevolent biodegradable polymers: Synthesis, biodegradability, and applications. In Cellulose Fibers: Bio- and Nano-Polymer Composites; Springer: Berlin/Heidelberg, Germany, 2011; pp. 425–451. [Google Scholar]
- Montgomery, D.C. Design and Analysis of Experiments, 5th ed.; Wiley: New York, NY, USA, 2001; p. 697. [Google Scholar]
- Hassan, M.; Berglund, L.; Abou-Zeid, R.; Hassan, E.; Abou-Elseoud, W.; Oksman, K. Nanocomposite film based on cellulose acetate and lignin-rich rice straw nanofibers. Materials 2019, 12, 595. [Google Scholar] [CrossRef]
- Chen, J.; Xu, J.; Wang, K.; Cao, X.; Sun, R. Cellulose acetate fibers prepared from different raw materials with rapid synthesis method. Carbohydr. Polym. 2016, 137, 685–692. [Google Scholar] [CrossRef]
- Chowdhury, M.A.; Hossain, N.; Noman, T.I.; Hasan, A.; Shafiul, A.; Abul, K.M. Biodegradable, physical and microbial analysis of tamarind seed starch infused eco-friendly bioplastic by different percentage of Arjuna powder. Results Eng. 2022, 13, 100387. [Google Scholar] [CrossRef]
- Huang, F.Y. Thermal properties and thermal degradation of cellulose tri-stearate (CTs). Polymers 2012, 4, 1012–1024. [Google Scholar] [CrossRef]
- Fortunati, E.; Pugliaa, D.; Luzia, F.; Santulli, C.; Kenny, J.M.; Torrea, L. Binary PVA bionanocomposites containing cellulose nanocrystals extracted from different natural sources. Carbohydr. Polym. 2013, 97, 825–836. [Google Scholar] [CrossRef] [PubMed]
- Melikoglu, A.Y.; Bilek, S.E.; Cesur, S. Optimum alkaline treatment parameters forthe extraction of cellulose and production of cellulose nanocrystals from apple pomace. Carbohydr. Polym. 2019, 215, 330–337. [Google Scholar] [CrossRef] [PubMed]
- Nigam, S.; Das, A.K.; Patidar, M.K. Valorization of Partheniumhy sterophorus weed for cellulose extraction andits application for bioplastic preparation. J. Environ. Chem. Eng. 2021, 9, 105424. [Google Scholar] [CrossRef]
- Al-Timimi, L.A.N. Antibacterial and Anticancer Activities of Fenugreek Seed Extract. Asian Pac. J. Cancer Prev. 2019, 20, 3771–3776. [Google Scholar] [CrossRef]

| Constituent | Moisture | Ash | Fat | Protein | Fiber | NFE |
|---|---|---|---|---|---|---|
| Percentages | 10.17 ± 0.06 | 2.63 ± 0.15 | 7.47 ± 0.31 | 27.55 ± 1.56 | 3.79 ± 0.31 | 48.39 ± 1.33 |
| Constituent | Moisture | Protein | Fat/Oil | Crude Fiber | Carbohydrates | Total Ash | Total Sugar |
|---|---|---|---|---|---|---|---|
| Percentages | 9.4–11.3 | 13.3–26.9 | 4.5–16.2 | 7.4–8.8 | 50.0–57.0 | 1.6–4.2 | 11.3–25.3 |
| Sample | Distilled Water | White Vinegar | Glycerol | Tamarind Seed Starch | Fenugreek Powder |
|---|---|---|---|---|---|
| S1 | 69% (360 mL) | 8% (40 mL) | 6% (30 mL) | 12% (60 gm) | 5% (26 gm) |
| S2 | 66% (360 mL) | 8% (40 mL) | 6% (30 mL) | 11% (60 gm) | 10% (54 gm) |
| S3 | 62% (360 mL) | 7% (40 mL) | 5% (30 mL) | 11% (60 gm) | 15% (85 gm) |
| Sample | Tensile Strength (MPa) | Standard Deviation | Tensile Strain (%) | Standard Deviation | Young’s Modulus (MPa) |
|---|---|---|---|---|---|
| S1 | 2.905 | 0.110 | 6.797 | 0.353 | 0.427 |
| S2 | 1.435 | 0.071 | 2.189 | 0.094 | 0.655 |
| S3 | 1.357 | 0.062 | 3.029 | 0.125 | 0.448 |
Publisher’s Note: MDPI stays neutral with regard to jurisdictional claims in published maps and institutional affiliations. |
© 2022 by the authors. Licensee MDPI, Basel, Switzerland. This article is an open access article distributed under the terms and conditions of the Creative Commons Attribution (CC BY) license (https://creativecommons.org/licenses/by/4.0/).
Share and Cite
Hossain, N.; Chowdhury, M.A.; Noman, T.I.; Rana, M.M.; Ali, M.H.; Alruwais, R.S.; Alam, M.S.; Alamry, K.A.; Aljabri, M.D.; Rahman, M.M. Synthesis and Characterization of Eco-Friendly Bio-Composite from Fenugreek as a Natural Resource. Polymers 2022, 14, 5141. https://doi.org/10.3390/polym14235141
Hossain N, Chowdhury MA, Noman TI, Rana MM, Ali MH, Alruwais RS, Alam MS, Alamry KA, Aljabri MD, Rahman MM. Synthesis and Characterization of Eco-Friendly Bio-Composite from Fenugreek as a Natural Resource. Polymers. 2022; 14(23):5141. https://doi.org/10.3390/polym14235141
Chicago/Turabian StyleHossain, Nayem, Mohammad Asaduzzaman Chowdhury, Tauhidul Islam Noman, Md. Masud Rana, Md. Hasan Ali, Raja Saad Alruwais, Md. Shafiul Alam, Khalid A. Alamry, Mahmood D. Aljabri, and Mohammed M. Rahman. 2022. "Synthesis and Characterization of Eco-Friendly Bio-Composite from Fenugreek as a Natural Resource" Polymers 14, no. 23: 5141. https://doi.org/10.3390/polym14235141
APA StyleHossain, N., Chowdhury, M. A., Noman, T. I., Rana, M. M., Ali, M. H., Alruwais, R. S., Alam, M. S., Alamry, K. A., Aljabri, M. D., & Rahman, M. M. (2022). Synthesis and Characterization of Eco-Friendly Bio-Composite from Fenugreek as a Natural Resource. Polymers, 14(23), 5141. https://doi.org/10.3390/polym14235141








